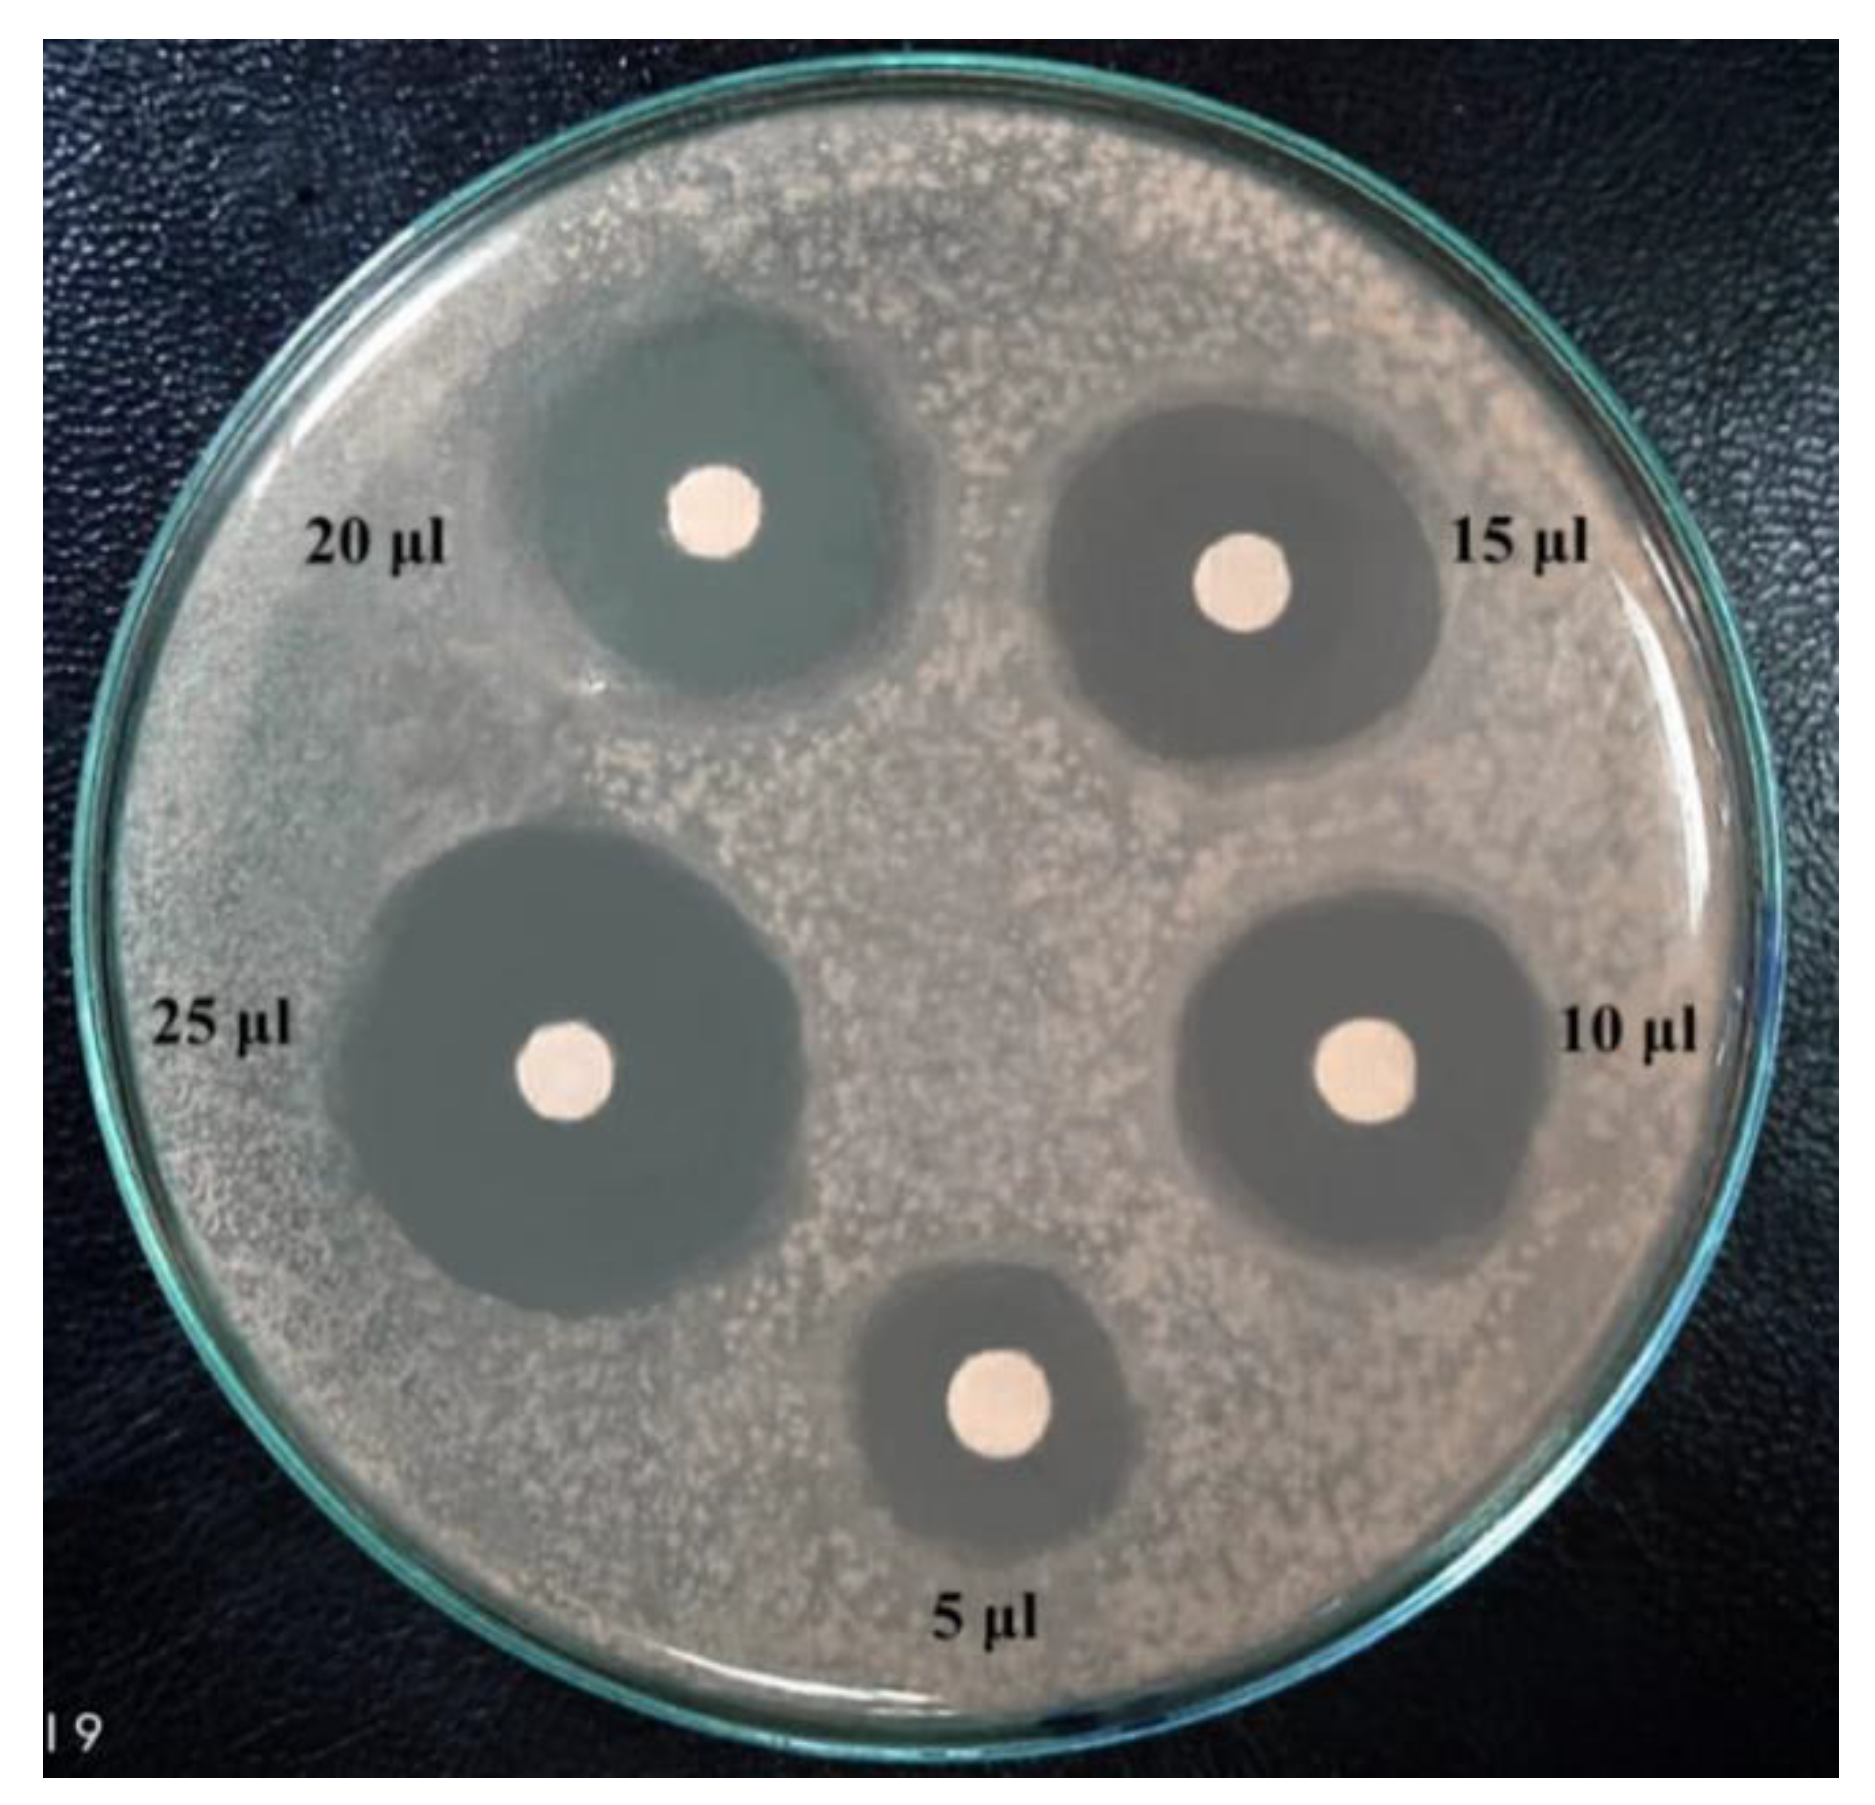

Enhancing the Antibiotic Production by Thermophilic Bacteria Isolated from Hot Spring Waters via Ethyl Methanesulfonate Mutagenesis
Abstract
1. Introduction
2. Results
2.1. Hot Spring Water and Saline-Affected Soils Used for Microbial Isolation
2.2. Isolation of Thermophilic and Halophilic Microbes
2.3. Screening Isolates for Antibiotic Production Using Standard Agar Disc Diffusion (SADD) Method
2.4. Molecular Identification of the Potent Antibiotic-Producing Bacterial Isolates 10 and 113
2.5. Antimicrobial Inhibitory Effect of Two Potent Bacterial Supernatants against Test Pathogenic Bacteria
2.6. Mutagenesis Using Ethyl Methanesulfonate (EMS)
2.7. Genetic Improvement of Antimicrobial-Producing Strains via Ethyl Methanesulfonate (EMS) Mutagenesis
3. Discussion
4. Material and Methods
4.1. Collection of Samples from Extreme Conditions
4.2. Isolation of Thermophilic and Halophilic Microbes
4.3. Screening Isolates for Antibiotic Production Using Standard Agar Disc Diffusion (SADD) Method
4.4. DNA Isolation and Molecular Identification of Bacterial Isolates
4.5. Phylogenetic Analysis
4.6. Antimicrobial Inhibitory Effect of Two Potent Bacterial Supernatants Obtained from Hot Spring Waters against Test Pathogenic Bacteria
4.7. Mutagenesis Using Ethyl Methanesulfonate (EMS)
4.8. Assessment of Antimicrobial Activity of the Mutants of B. licheniformis 113 and Br. borstelensis 10
4.9. Statistical Analysis
5. Conclusions
Author Contributions
Funding
Institutional Review Board Statement
Informed Consent Statement
Data Availability Statement
Acknowledgments
Conflicts of Interest
References
- O’Brien, J.; Wright, G.D. An ecological perspective of microbial secondary metabolism. Curr. Opin. Biotechnol. 2011, 22, 552–558. [Google Scholar] [CrossRef] [PubMed]
- Okada, B.K.; Seyedsayamdost, M.R. Antibiotic dialogues: Induction of silent biosynthetic gene clusters by exogenous small molecules. FEMS Microbiol. Rev. 2017, 41, 19–33. [Google Scholar] [CrossRef] [PubMed]
- Ebou, A.; Koua, D.; Addablah, A.; Kakou-Ngazoa, S.; Dutertre, S. Combined proteotranscriptomic-based strategy to discover novel antimicrobial peptides from cone snails. Biomedicines 2021, 9, 344. [Google Scholar] [CrossRef] [PubMed]
- Valarmathi, P. Antibiotics-miracle drugs as crop protectants: A review. Agric. Rev. 2020, 41, 43–50. [Google Scholar] [CrossRef]
- Kolter, R.; Van Wezel, G.P. Goodbye to brute force in antibiotic discovery? Nat. Microbiol. 2016, 1, 15020. [Google Scholar] [CrossRef]
- Mamun, M.M.; Sorinolu, A.J.; Munir, M.; Vejerano, E.P. Nanoantibiotics: Functions and properties at the nanoscale to combat antibiotic resistance. Front. Chem. 2021, 9, 348. [Google Scholar] [CrossRef]
- Aminov, R. History of antimicrobial drug discovery: Major classes and health impact. Biochem. Pharmacol. 2017, 133, 4–19. [Google Scholar] [CrossRef]
- Khan, D.A. Proactive management of penicillin and other antibiotic allergies. Allergy Asthma Proc. 2020, 41, 82–89. [Google Scholar] [CrossRef]
- Duval, R.E.; Grare, M.; Demoré, B. Fight against antimicrobial resistance: We always need new antibacterials but for right bacteria. Molecules 2019, 24, 3152. [Google Scholar] [CrossRef]
- Hu, X.Y.; Logue, M.; Robinson, N. Antimicrobial resistance is a global problem—A UK perspective. Eur. J. Integr. Med. 2020, 36, 101136. [Google Scholar] [CrossRef]
- Abd El-Rahim, W.M.; Moawad, H.; Khalafallah, M. Enhancing the growth of promising fungal strains for rapid dye removal. Fresenius Environ. Bull. 2003, 12, 764–770. [Google Scholar]
- Abd El-Rahim, W.M.; Moawad, H.; Azeiz, A.Z.A.; Sadowsky, M.J. Biodegradation of azo dyes by bacterial or fungal consortium and identification of the biodegradation products. Egypt. J. Aquat. Res. 2021, 47, 269–276. [Google Scholar] [CrossRef]
- Elazm, A.A.; Abd El-Rahim, W.M.; Moawad, H.; Zaki, S.; Sedik, M.Z.; Rostom, M. Bioremediation of hexavalent chromium widely discharged in leather tanning effluents. Egypt. J. Chem. 2020, 63, 2201–2212. [Google Scholar] [CrossRef]
- Abd El-Rahim, W.M.; Moawad, H.; Hashem, M.M.; Gebreil, G.M.; Zakaria, M. Highly efficient fungal pectinase and laccase producers among isolates from flax retting liquor. Biocatal. Agric. Biotechnol. 2020, 25, 101570. [Google Scholar] [CrossRef]
- Moawad, H.; Abd el-Rahim, W.M.; Abd el-Aleem, D.; Abo Sedera, S.A. Persistence of two Rhizobium etli inoculant strains in clay and silty loam soils. J. Basic Microbiol. Int. J. Biochem. Physiol. Genet. Morphol. Ecol. Microorg. 2005, 45, 438–446. [Google Scholar]
- Dafale, N.A.; Srivastava, S.; Purohit, H.J. Zoonosis: An emerging link to antibiotic resistance under “One health approach”. Indian J. Microbiol. 2020, 60, 139–152. [Google Scholar] [CrossRef]
- Smith, R.; Russo, J.; Fiegel, J.; Brogden, N. Antibiotic delivery strategies to treat skin infections when innate antimicrobial defense fails. Antibiotics 2020, 9, 56. [Google Scholar] [CrossRef]
- Jakubiec-Krzesniak, K.; Rajnisz-Mateusiak, A.; Guspiel, A.; Ziemska, J.; Solecka, J. Secondary metabolites of actinomycetes and their antibacterial, antifungal and antiviral properties. Pol. J. Microbiol. 2018, 67, 259. [Google Scholar] [CrossRef]
- Jaroszewicz, W.; Bielańska, P.; Lubomska, D.; Kosznik-Kwaśnicka, K.; Golec, P.; Grabowski, Ł.; Węgrzyn, A. Antibacterial, antifungal and anticancer activities of compounds produced by newly isolated Streptomyces strains from the Szczelina Chochołowska cave (Tatra Mountains, Poland). Antibiotics 2021, 10, 1212. [Google Scholar] [CrossRef]
- Kumar, P.S.; Duraipandiyan, V.; Ignacimuthu, S. Szczelina Chochołowska cave Isolation, screening and partial purification of antimicrobial antibiotics from soil Streptomyces sp. SCA 7. Kaohsiung J. Med. Sci. 2014, 30, 435–446. [Google Scholar] [CrossRef]
- Coates, A.R.; Hu, Y.; Holt, J.; Yeh, P. Antibiotic combination therapy against resistant bacterial infections: Synergy, rejuvenation and resistance reduction. Expert Rev. Anti-Infect. Ther. 2020, 18, 5–15. [Google Scholar] [CrossRef] [PubMed]
- Moawad, H.; Abd El-Rahim, W.M.; Abd El-Haleem, D. Performance of Phaseolus bean rhizobia in soils from the major production sites in the Nile Delta. Comptes Rendus Biol. 2004, 327, 445–453. [Google Scholar] [CrossRef] [PubMed]
- Abd El-Rahim, W.M.; Khalil, W.K.; Eshak, M.G. Evaluation of the gene expression changes in Nile tilapia (Oreochromis niloticus) as affected by the bio-removal of toxic textile dyes from aqueous solution in small-scale bioreactor. Environmentalist 2010, 30, 242–253. [Google Scholar] [CrossRef]
- Moawad, H.; Abd El-Rahim, W.M.; Mohamed, W.; Hashem, M.M.; Gebreil, G.M.; Sabbor, A.; Sedik, M.Z. Retting and degumming of flax using biotechnology eco-friendly approach. Egypt. J. Chem. 2019, 62, 2033–2045. [Google Scholar] [CrossRef]
- Moawad, H.; Abd El-Rahim, W.M.; Gebreil, G.M.; Hashem, M.M.; Zakaria, M. Historical developments of flax industry for improving fibers quality and fabrics properties. Cut.-Edge Res. Agric. Sci. 2021, 5, 55–74. [Google Scholar]
- Yang, H.; Paruch, L.; Chen, X.; van Eerde, A.; Skomedal, H.; Wang, Y.; Liu Clarke, J. Antibiotic application and resistance in swine production in China: Current situation and future perspectives. Front. Vet. Sci. 2019, 6, 136. [Google Scholar] [CrossRef]
- De Souza, J.P.; do Prado, C.D.; Eleutherio, E.C.; Bonatto, D.; Malavazi, I.; da Cunha, A.F. Improvement of Brazilian bioethanol production–Challenges and perspectives on the identification and genetic modification of new strains of Saccharomyces cerevisiae yeasts isolated during ethanol process. Fungal Biol. 2018, 122, 583–591. [Google Scholar] [CrossRef]
- El-Sherbini, A.; Khattab, A.A. Induction of novel mutants of Streptomyces lincolnensis with high lincomycin production. J. Appl. Pharm. Sci. 2018, 8, 128–135. [Google Scholar]
- Osman, Y.; Mowafy, A.; Abdelrazak, A.; El-Mallah, A. Identification of four thermophilic Geobacillus isolates from Hammam Pharaon, Sinai, Egypt. J. Agric. Chem. Biotechnol. 2018, 9, 151–157. [Google Scholar] [CrossRef]
- Moubasher, A.H.; Ismail, M.A.; Al-Bedak, O.A.; Mohamed, R.A. Ramophialophora chlamydospora, a new species from an alkaline lake of Wadi-El-Natron. Egypt Asian J. Mycol. 2019, 2, 110–117. [Google Scholar] [CrossRef]
- Kimura, R.; Iwasaki, E.; Matsuoka, N. Analysis of the recent agricultural situation of Dakhla Oasis, Egypt, using meteorological and satellite data. Remote Sens. 2020, 12, 1264. [Google Scholar] [CrossRef]
- ElSharayidi, M.S.; Dewidar, A.; Shafik, H. Molecular characterization of thermostable hydrolytic Enzymes producing bacteria isolated from hot spring of Ras Sedr, South Sinai, Egypt. Alfarama J. Basic Appl. Sci. 2021, 2, 60–69. [Google Scholar] [CrossRef]
- El-Rawy, M.; Abdalla, F.; Negm, A.M. Groundwater Characterization and Quality Assessment in Nubian Sandstone Aquifer, Kharga Oasis, Egypt. In Groundwater in Egypt’s Deserts; Springer: Cham, Switzerland, 2021; pp. 177–199. [Google Scholar]
- Hagagy, N.I.; Saddiq, A.A.; Hamedo, H.A.; Selim, S.A. Extremophiles inhabiting unique ecosystems in Egypt. In Extreme Environments; CRC Press: Boca Raton, FL, USA, 2021; pp. 252–262. [Google Scholar]
- Panosyan, H. Thermophilic and halophilic prokaryotes isolated from extreme environments of Armenia and their biotechnological potential. In Microbial Versatility in Varied Environments: Microbes in Sensitive Environments; Springer: Berlin/Heidelberg, Germany, 2020; pp. 13–34. [Google Scholar]
- Fariq, A.; Yasmin, A. Production, characterization and bioactivities of biosurfactants from newly isolated strictly halophilic bacteria. Process Biochem. 2020, 98, 1–10. [Google Scholar] [CrossRef]
- Silvia, S.; Donahue, S.A.; Killeavy, E.E.; Jogl, G.; Gregory, S.T. A Survey of spontaneous antibiotic-resistant mutants of the halophilic, thermophilic bacterium Rhodothermus marinus. Antibiotics 2021, 10, 1384. [Google Scholar] [CrossRef]
- Banoon, S.; Ali, Z.; Salih, T. Antibiotic resistance profile of local thermophilic Bacillus licheniformis isolated from Maysan province soil. Comun. Sci. 2020, 11, e3291. [Google Scholar] [CrossRef]
- Gahamanyi, N.; Mboera, L.E.; Matee, M.I.; Mutangana, D.; Komba, E.V. Prevalence, risk factors, and antimicrobial resistance profiles of thermophilic Campylobacter species in humans and animals in sub-saharan Africa: A systematic review. Int. J. Microbiol. 2020, 2020, 2092478. [Google Scholar] [CrossRef]
- Ak, A.U.; Demirkan, E.; Cengiz, M.; Sevgi, T.; Zeren, B.; Abdou, M. Optimization of culture medium for the production and partial purification and characterization of an antibacterial activity from Brevibacillus laterosporus strain EA62. Rom. Biotechnol. Lett. 2019, 24, 705–713. [Google Scholar]
- Halami, P.M. Sublichenin, a new subtilin-like lantibiotics of probiotic bacterium Bacillus licheniformis MCC 2512T with antibacterial activity. Microb. Pathog. 2019, 128, 139–146. [Google Scholar] [CrossRef]
- Boovaragamoorthy, G.M.; Anbazhagan, M.; Piruthiviraj, P.; Pugazhendhi, A.; Kumar, S.S.; Al-Dhabi, N.A.; Kaliannan, T. Clinically important microbial diversity and its antibiotic resistance pattern towards various drugs. J. Infect. Public Health 2019, 12, 783–788. [Google Scholar] [CrossRef]
- Zhao, S.; Chen, J.; Fei, P.; Feng, H.; Wang, Y.; Ali, M.A.; Yang, W. Prevalence, molecular characterization, and antibiotic susceptibility of Bacillus cereus isolated from dairy products in China. J. Dairy Sci. 2020, 103, 3994–4001. [Google Scholar] [CrossRef]
- Ikram-Ul-Haq, S.; Saleem, A.; Javed, M.M. Mutagenesis of Bacillus licheniformis through ethyl methane sulfonate for alpha amylase production. Pak. J. Bot. 2009, 41, 1489–1498. [Google Scholar]
- Wang, L.; Xia, Y.; Su, L.; Wu, J. Modification of Bacillus clarkii γ-cyclodextrin glycosyltransferase and addition of complexing agents to increase γ-cyclodextrin production. J. Agric. Food Chem. 2020, 68, 12079–12085. [Google Scholar] [CrossRef] [PubMed]
- Rasul, S. Isolation and Mutagenesis of a Bacterial Strain for Enhanced Production and Characterization of Organophosphate Hydrolase. Doctoral Dissertation, University of Agriculture, Faisalabad, Pakistan, 2015. [Google Scholar]
- Dat, L.K.; Hien, P.T.T.; Loi, T.T.; Ha, P.T.T. The effect of Ethyl methanesulfonate and Methylsalicylate induced on physiologicaland biochemical characteristics of rice OMCS2000 in anaerobic germination and plant growth under waterlogging. Res. Sq. 2022, 1–21. [Google Scholar] [CrossRef]
- Khattab, A.E.N.; Darwish, A.M.; Othman, S.I.; Allam, A.A.; Alqhtani, H.A. Anti-inflammatory and immunomodulatory potency of selenium-enriched probiotic mutants in mice with induced ulcerative colitis. Biol. Trace Elem. Res. 2022, 201, 353–367. [Google Scholar] [CrossRef]
- McAuley, S.; Huynh, A.; Howells, A.; Walpole, C.; Maxwell, A.; Nodwell, J.R. Discovery of a novel DNA gyrase-targeting antibiotic through the chemical perturbation of Streptomyces venezuelae sporulation. Cell Chem. Biol. 2019, 26, 1274–1282. [Google Scholar] [CrossRef]
- Hindra Pak, P.; Elliot, M.A. Regulation of a novel gene cluster involved in secondary metabolite production in Streptomyces coelicolor. J. Bacteriol. 2010, 192, 4973–4982. [Google Scholar] [CrossRef]
- EL-Bondkly, A.M.; Khattab, A.A. Clavulanic acid and cephamycin improvement in Streptomyces clavuligerus by inducing combined resistant mutations and protoplast fusion. Egypt. J. Genet. Cytol. 2004, 33, 217–230. [Google Scholar]
- Qattan, S.Y.; Kattab, A.A. Gentamicin production by cultural optimization system and genetically improved mutants of Micromonospora echinospora. Pharmacophore 2020, 11, 15–26. [Google Scholar]
- Khalil, M.A.; Beltagy, E.A.; Elshouny, W.A.; El-Naga, E.H.A.; Elshenawy, M.A.; Kelany, M.S. Seasonal bacteriological and physico-chemical analysis of Lake Timsah, Ismailia, Egypt. Life Sci. J. 2014, 11, 10. [Google Scholar]
- Mulango, E.; Kasili, R.; Mwirichia, R.; Kambura, A.K.; Muhonja, C. Isolation and characterization of haloalkaliphilic bacteria from the hot springs of Lake Magadi. Afr. J. Microbiol. Res. 2020, 14, 294–302. [Google Scholar]
- Mulango, E.M. Isolation and Characterization of Extremophilic Bacteria from the Hot Springs of Lake Magadi, Kenya. Doctoral Dissertation, JKUAT-IBR, Nairobi, Kenya, 2020. [Google Scholar]
- Benkova, M.; Soukup, O.; Marek, J. Antimicrobial susceptibility testing: Currently used methods and devices and the near future in clinical practice. J. Appl. Microbiol. 2020, 129, 806–822. [Google Scholar] [CrossRef]
- Kortam, Y.G.; Abd El-Rahim, W.M.; Barakat, O.S.; Segai, U.M.; Zakaria, M.; Moawad, H. Optimization of antibiotic production against Bacillus cereus by a mutant strain of Bacillus licheniformis isolated from Egyptian Hamam Pharaon hot springs. Egypt. Pharm. J. 2022, 21, 502. [Google Scholar]
- Weisburg, W.G.; Barns, S.M.; Pelletier, D.A.; Lane, D.J. 16S ribosomal DNA amplification for phylogenetic study. J. Bacteriol. 1991, 173, 697–703. [Google Scholar] [CrossRef]
- Liao, Y.; Chen, J.; Brandt, B.W.; Zhu, Y.; Li, J.; van Loveren, C.; Deng, D.M. Identification and functional analysis of genome mutations in a fluoride-resistant Streptococcus mutans strain. PLoS ONE 2015, 10, e0122630. [Google Scholar] [CrossRef]
- Iličić, R.; Jelušić, A.; Marković, S.; Barać, G.; Bagi, F.; Popović, T. Pseudomonas cerasi, the new wild cherry pathogen in Serbia and the potential use of recG helicase in bacterial identification. Ann. Appl. Biol. 2022, 180, 140–150. [Google Scholar] [CrossRef]
- Altschul, S.F.; Madden, T.L.; Schäffer, A.A.; Zhang, J.; Zhang, Z.; Miller, W.; Lipman, D.J. Gapped BLAST and PSI-BLAST: A new generation of protein database search programs. Nucleic Acids Res. 1997, 25, 3389–3402. [Google Scholar] [CrossRef]
- Kumar, S.; Stecher, G.; Li, M.; Knyaz, C.; Tamura, K. MEGA X: Molecular evolutionary genetics analysis across computing platforms. Mol. Biol. Evol. 2018, 35, 1547. [Google Scholar] [CrossRef]
- Kaunietis, A.; Buivydas, A.; Čitavičius, D.J.; Kuipers, O.P. Heterologous biosynthesis and characterization of a glycocin from a thermophilic bacterium. Nat. Commun. 2019, 10, 1–12. [Google Scholar]
- Tyagi, S.; Singh, R.K.; Tiwari, S.P. Anti-enterococcal and anti-oxidative potential of a thermophilic cyanobacterium, Leptolyngbya sp. HNBGU 003. Saudi J. Biol. Sci. 2021, 28, 4022–4028. [Google Scholar] [CrossRef]
- Bazaraa, W.A.; Abd El-Hafez, A.E.N.; Ibrahim, E.M. Mutagenesis and protoplast fusion for enhanced bacteriocins production. Appl. Food Biotechnol. 2021, 8, 133–142. [Google Scholar]
- Manandhar, S.; Luitel, S.; Dahal, R.K. In vitro antimicrobial activity of some medicinal plants against human pathogenic chemicals and drugs. BMC Res. Notes 2009, 2, 185. [Google Scholar]

| Sample Type | Sample No. | Sampling Sites | Temp. °C | EC dS/m | Dissolved Cations mEq/L | Dissolved Anions mEq/L | |||||
|---|---|---|---|---|---|---|---|---|---|---|---|
| Ca2+ | Mg2+ | Na+ | K+ | HCO3− | Cl− | SO42− | |||||
| Water | 1 | Hot spring at Ras Sedr, Sinai | 90 | 7.05 | 13.2 | 53 | 30 | 131 | 2.16 | 130 | 83.34 |
| 2 | Hot spring at El-Baida Lake, Wadi El-Natrun | 60 | 8.16 | 17.58 | 8 | 11.5 | 21 | 1.8 | 17 | 23.7 | |
| 3 | Suez Gulf, Sinai | 25 | 7.68 | 63.1 | 31 | 138 | 745.3 | 1.8 | 643 | 274.1 | |
| 4 | Salinity Al-Gaar Lake, Wadi El-Natrun | 28 | 9.27 | 177 | 130 | 190 | 1456 | 110 | 1620 | 53.2 | |
| 5 | Salinity El-Hamara Lake, Wadi El-Natrun | 28 | 8.02 | 329 | 55 | 116.5 | 2488 | 39.6 | 2592 | 34.1 | |
| 6 * | Hammam Pheraon hot springs (entrance) | 50 | 7.07 | 25.1 | 62 | 28 | 220.3 | 0.9 | 250 | 62.5 | |
| 7 * | Hammam Pheraon hot springs (inside) | 55 | 7.69 | 27.5 | 84 | 44 | 268.1 | 1.3 | 285 | 113.2 | |
| 8 * | Ras Sedr sulfur hot spring | 90 | 7.05 | 15.37 | 47 | 16 | 101 | 0.7 | 114 | 51.4 | |
| 9 * | Dakhla Oasis hot spring | 51 | 8.16 | 4.28 | 8 | 11.5 | 21 | 1.8 | 17 | 23.7 | |
| 10 * | Kharga Oasis hot spring | 55 | 9.66 | 0.71 | 2 | 2 | 3.5 | 1.3 | 4 | 2.32 | |
| Soils | 11 | Inside hot spring of Hammam Pharaon, Sinai | 55 | 7.78 | 29.2 | 89 | 47 | 287.6 | 1.9 | 321 | 124 |
| 12 | El-Baida Lake, Wadi El-Natrun | 60 | 9.66 | 19.12 | 2 | 2 | 3.5 | 1.3 | 4 | 2.32 | |
| 13 | Rhizosphere samples from the Suez Gulf coast, Sinai | 30 | 7.83 | 65.4 | 38.4 | 146 | 873 | 2.9 | 759 | 298 | |
| 14 | Salinity Al-Gaar Lake, Wadi El-Natrun, | 28 | 9.04 | 181 | 136 | 197 | 1489 | 117 | 1690 | 61.5 | |
| 15 | Salinity El-Hamara Lake, Wadi El-Natrun, | 28 | 8.18 | 358 | 61 | 127 | 2617 | 43.8 | 2619 | 38.5 | |
| Sample Type | Sample Sites | Sample Number | Production of Antibiotics against 8 Pathogenic Test Microorganisms * | 17 | |
|---|---|---|---|---|---|
| Positive | Negative | ||||
| Water | Ras Sedr hot spring, Sinai | 1 | 5 | 12 | 17 |
| El-Baida Lake hot spring, Wadi El-Natrun | 2 | 3 | 10 | 13 | |
| Suez Gulf, Sinai | 3 | 4 | 13 | 17 | |
| Salinity Al-Gaar Lake, Wadi El-Natrun | 4 | 1 | 17 | 18 | |
| Salinity El-Hamara Lake, Wadi El-Natrun | 5 | 3 | 21 | 24 | |
| Hammam Pheroon hot springs (entrance) | 6 | 5 | 7 | 12 | |
| Hammam Pheroon hot springs (inside) | 7 | 4 | 11 | 15 | |
| Ras Sedr sulfur hot spring | 8 | 2 | 16 | 18 | |
| Dakhla Oasis hot spring | 9 | 6 | 7 | 13 | |
| Kharga Oasis hot spring | 10 | 5 | 14 | 19 | |
| Soils | Hammam Pharaon hot spring, Sinai | 11 | 7 | 18 | 25 |
| El-Baida Lake, Wadi El-Natrun | 12 | 2 | 17 | 19 | |
| Rhizosphere samples from the Suez Gulf coast, Sinai | 13 | 3 | 16 | 19 | |
| Al-Gaar Lake, Wadi El-Natrun, | 14 | 1 | 23 | 24 | |
| El-Hamara Lake, Wadi El-Natrun, | 15 | 1 | 26 | 27 | |
| Totals | - | - | 52 | 228 | 280 |
| Isolate Source | Isolate Number | Sample Sites | Pathogenic Test Bacteria | Spectrum of Antagonism against 8 Pathogens | |||||||
|---|---|---|---|---|---|---|---|---|---|---|---|
| B. cereus | B. subtilis | E. coli | S. typhi | Klebs sp. | S. aureus | M. luteus | P. ariuginosa | ||||
| Water | 10 | Kharga Oasis 1 * | + | + | + | + | + | + | + | + | 8 |
| 113 | Hammam Pheraon 1 | + | + | + | + | + | + | + | + | 8 | |
| 118, 116 | El-Hamara Lake 1 | − | + | + | + | + | + | + | + | 7 | |
| 9, 11 | Dakhla Oasis 1 | − | + | − | + | + | + | + | + | 6 | |
| 131, 124 | Ras Sedr 1 | + | + | + | + | + | + | − | + | 7 | |
| 111 | Hammam Pheraon 1 | − | + | + | + | + | − | + | + | 6 | |
| 109, 108 | Suez Gulf 1 | − | + | + | + | − | + | + | + | 6 | |
| 19 | Dakhla Oasis 1 | + | + | + | + | + | − | + | − | 6 | |
| 112 | Hammam Pheraon 1 | + | + | + | + | + | − | + | − | 6 | |
| 121, 123 | Hammam Pheraon 2* | − | + | + | − | + | − | + | + | 5 | |
| 123, 149 | Suez Gulf 1 | + | + | + | − | − | − | + | − | 4 | |
| 114, 126 | El-Baida Lake 1 | − | − | + | − | + | + | + | + | 5 | |
| 120 | El-Hamara Lake 1 | − | − | + | − | + | + | + | + | 5 | |
| 122 | Ras Sedr 1 | − | − | + | − | + | + | + | + | 5 | |
| 22, 20, 13 | Dakhla Oasis 1 | − | − | + | − | + | + | + | + | 5 | |
| 119, 124 | Hammam Pheroon 1 | − | + | − | + | + | − | + | + | 5 | |
| 115, 125 | Ras Sedr 1 | − | + | − | + | + | − | + | + | 5 | |
| 3, 8 | Kharga Oasis 1 | + | + | + | − | − | − | + | + | 5 | |
| 25 | Ras Sedr sulfur 2 | − | − | − | + | + | + | + | + | 5 | |
| 141, 143 | Hammam Pheraon 2 | − | − | − | + | + | + | + | + | 5 | |
| 191 | Ras Sedr sulfur 2 | − | − | − | + | + | + | + | + | 5 | |
| 155 | Al-Gaar Lake 1 | + | − | − | + | − | − | − | − | 2 | |
| 147 | El-Baida Lake 1 | + | + | − | − | − | − | − | − | 2 | |
| 1, 5 | Kharga Oasis 1 | − | − | + | − | − | − | − | − | 1 | |
| Soils | 136, 138 | Hammam Pharaon 3* | − | − | − | + | + | + | + | + | 5 |
| 130 | Al-Gaar Lake 2 | + | + | + | − | − | − | + | − | 4 | |
| 135, 127 | Hammam Pharaon 3 | + | + | − | + | + | + | + | + | 7 | |
| 225 | El-Baida Lake 2 | + | + | + | − | − | − | + | − | 4 | |
| 128 | Hammam Pharaon 3 | − | − | + | − | + | + | + | + | 5 | |
| 158 | Suez Gulf coast 2 | − | − | + | − | + | + | + | + | 5 | |
| 229 | El-Baida Lake 2 | − | − | + | − | + | + | + | + | 5 | |
| 182, 23 | Hammam Pharaon 3 | + | + | − | − | + | + | − | − | 4 | |
| 157, 154 | Suez Gulf coast 2 | − | + | + | − | − | − | + | − | 3 | |
| 184 | El-Hamara Lake 2 | + | − | − | + | − | − | − | − | 2 | |
| 156 | Hammam Pharaon 3 | − | + | − | − | − | − | − | − | 1 | |
| Test Bacteria | MIE of Bacterial Culture Supernatant (μL) Containing (AM) | |
|---|---|---|
| B. licheniformis 113 | Br. borstelensis 10 | |
| B. cereus | 15 | 5 |
| B. subtilis | 10 | 10 |
| E. coli | 15 | 10 |
| S. typhimurium | 10 | 15 |
| K. pneumonia | 20 | 10 |
| S. aureus | 5 | 10 |
| M. luteus | 10 | 15 |
| P. aeruginosa | 5 | 25 |
| Bacterial Strains | Diameter of Inhibition Zone (mm) | ||||||||||||
|---|---|---|---|---|---|---|---|---|---|---|---|---|---|
| VAN +30 | GEN 10 | OTC 10 | NEO 5 | Tet 30 | R-SV 30 | PM-B 300 | NOR 10 | AMX 25 | KAN 30 | STR 10 | ERY 15 | C 10 | |
| B. licheniformis, 113 | 0 | 11 | 0 | 0 | 8 | 26 | 16 | 12 | 8 | 0 | 0 | 0 | 18 |
| Br. borstelensis, 10 | 0 | 8 | 12 | 8 | 9 | 0 | 9 | 16 | 0 | 13 | 0 | 15 | 24 |
| Period (min) | B. licheniformis 113 | Br. borstelensis 10 | ||
|---|---|---|---|---|
| Count CFU/mL | Survival % | Count CFU/mL | Survival % | |
| 0 | 78 × 106 | 100 | 169 × 106 | 100 |
| 20 | 45 × 106 | 57.7 | 62 × 106 | 36.6 |
| 40 | 38 × 106 | 48.8 | 14 × 106 | 8.3 |
| 60 | 11 × 106 | 41.2 | 8 × 106 | 4.8 |
| Mutant Strains | Inhibition Zone (mm) with Test Pathogenic Bacteria | |||||||
|---|---|---|---|---|---|---|---|---|
| B. cereusa | B. subtilisb | E. colia | S. typhic | K. pneumoniab | S. aureusd | M. luteusc | P. aeruginosaa | |
| Parent h | 22 la ± 0.05 | 19 mc ± 0.00 | 22 ja ± 0.00 | 10 je ± 0.05 | 17 ld ± 0.00 | 8 lf ± 0.05 | 8 kf ± 0.00 | 21 lb ± 0.00 |
| * M1/Van ef | 31 da ± 0.05 | 24 id ± 0.00 | 28 eb ± 0.05 | 16 ef ± 0.00 | 23 ge ± 0.00 | 13 gg ± 0.05 | 11 jh ± 0.00 | 26 hc ± 0.05 |
| M2/Van fg | 26 hb ± 0.00 | 26 gb ± 0.00 | 24 hd ± 0.00 | 13 ge ± 0.05 | 28 da ± 0.00 | 9 kf ± 0.00 | 13 ie ± 0.05 | 25 ic ± 0.00 |
| M3/Van g | 24 ja ± 0.00 | 23 jb ± 0.00 | 24 ha ± 0.00 | 18 dd ± 0.00 | 19 kc ± 0.00 | 11 if ± 0.00 | 17 ee ± 0.00 | 24 ja ± 0.00 |
| M4/Van fg | 30 ea ± 0.00 | 25 hc ± 0.05 | 24 hd ± 0.00 | 12 hg ± 0.00 | 24 fd ± 0.00 | 15 ee ± 0.05 | 14 hf ± 0.00 | 27 gb ± 0.10 |
| M5/Gen fg | 23 kb ± 0.05 | 23 jb ± 0.00 | 26 fa ± 0.00 | 14 fc ± 0.00 | 26 ea ± 0.05 | 9 ke ± 0.00 | 11 jd ± 0.00 | 26 ha ± 0.00 |
| M6/Oxy efg | 29 fb ± 0.05 | 24 id ± 0.00 | 25 gc ± 0.05 | 14 ff ± 0.00 | 23 ge ± 0.05 | 12 hg ± 0.00 | 11 jh ± 0.00 | 32 ca ± 0.00 |
| M7/Oxy g | 24 jc ± 0.00 | 20 le ± 0.00 | 23 id ± 0.00 | 13 gg ± 0.05 | 26 eb ± 0.00 | 14 ff ± 0.00 | 14 hf ± 0.05 | 29 ea ± 0.00 |
| M8/Neo b | 33 ba ± 0.00 | 32 bb ± 0.00 | 33 ba ± 0.10 | 22 bd ± 0.00 | 31 bc ± 0.00 | 21 be ± 0.05 | 22 bd ± 0.00 | 33 ba ± 0.00 |
| M9/Neo efg | 26 hb ± 0.05 | 23 jc ± 0.00 | 26 fb ± 0.05 | 11 ie ± 0.00 | 29 ca ± 0.00 | 9 kf ± 0.05 | 19 dd ± 0.00 | 23 kc ± 0.00 |
| M10/Tetra de | 24 jc ± 0.00 | 22 kd ± 0.05 | 26 fb ± 0.00 | 21 ce ± 0.00 | 31 ba ± 0.00 | 17 cf ± 0.00 | 16 fg ± 0.05 | 26 hb ± 0.05 |
| M11/Kan efg | 29 fb ± 0.00 | 30 da ± 0.05 | 28 ec ± 0.00 | 12 hg ± 0.05 | 22 he ± 0.05 | 9 kh ± 0.00 | 14 hf ± 0.00 | 23 kd ± 0.05 |
| M12/Kan fg | 25 ic ± 0.00 | 26 gb ± 0.00 | 31 ca ± 0.00 | 14 fg ± 0.05 | 20 je ± 0.00 | 14 fg ± 0.00 | 17 ef ± 0.00 | 23 kd ± 0.05 |
| M13/Str ef | 25 ic ± 0.05 | 25 hc ± 0.00 | 28 eb ± 0.00 | 16 ee ± 0.00 | 23 gd ± 0.00 | 10 jg ± 0.05 | 14 hf ± 0.05 | 29 ea ± 0.00 |
| M14/Chl ef | 28 ga ± 0.00 | 28 ea ± 0.00 | 24 hc ± 0.00 | 14 fe ± 0.00 | 26 eb ± 0.05 | 11 if ± 0.00 | 15 gd ± 0.00 | 26 hb ± 0.00 |
| M15/Amo a | 36 aa ± 0.00 | 33 ac ± 0.00 | 35 ab ± 0.00 | 24 ae ± 0.05 | 33 ac ± 0.00 | 25 ad ± 0.00 | 24 ae ± 0.00 | 36 aa ± 0.00 |
| M16/Ery d | 25 ic ± 0.00 | 31 ca ± 0.05 | 28 eb ± 0.05 | 18 df ± 0.00 | 21 id ± 0.00 | 16 dg ± 0.00 | 20 ce ± 0.00 | 28 fb ± 0.05 |
| M17/Ery c | 32 ca ± 0.05 | 27 fd ± 0.00 | 30 dc ± 0.00 | 14 ff ± 0.00 | 31 bb ± 0.00 | 14 ff ± 0.05 | 15 ge ± 0.00 | 31 db ± 0.00 |
| Mutant Strains | Inhibition Zones (mm) of Test Pathogenic Bacteria | |||||||
|---|---|---|---|---|---|---|---|---|
| B. cereusb | B. subtiliscd | E. colia | S. typhif | K. pneumoniae | S. aureusg | M. luteusde | P. aeruginosabc | |
| Parent f | 23 kb ± 0.00 | 19 ke ± 0.05 | 25 ka ± 0.00 | 18 lf ± 0.05 | 19 he ± 0.00 | 11 ig ± 0.05 | 20 md ± 0.00 | 21 hc ± 0.00 |
| * B1/Van e | 27 ga ± 0.10 | 23 hd ± 0.00 | 27 ia ± 0.00 | 23 id ± 0.00 | 26 eb ± 0.00 | 13 hf ± 0.00 | 22 le ± 0.00 | 25 fc ± 0.05 |
| B2/Van e | 24 jc ± 0.00 | 24 gc ± 0.05 | 29 ga ± 0.00 | 26 fb ± 0.00 | 23 gd ± 0.05 | 16 ee ± 0.05 | 23 kd ± 0.00 | 26 eb ± 0.00 |
| B3/Gen bcd | 28 fc ± 0.05 | 29 eb ± 0.00 | 32 ea ± 0.00 | 19 k ± 0.02 | 24 fe ± 0.05 | 18 cf ± 0.00 | 27 gd ± 0.05 | 28 dc ± 0.00 |
| B4/Gen bcd | 32 db ± 0.00 | 22 ig ± 0.00 | 34 ca ± 0.05 | 28 dc ± 0.00 | 27 dd ± 0.00 | 13 hh ± 0.00 | 23 k f ± 0.00 | 26 ee ± 0.05 |
| B5/Neo bcd | 26 he ± 0.00 | 32 ca ± 0.00 | 31 fb ± 0.00 | 25 gf ± 0.05 | 29 cc ± 0.00 | 16 eh ± 0.05 | 28 fd ± 0.00 | 23 gg ± 0.00 |
| B6/Neo d | 26 hc ± 0.00 | 25 fd ± 0.00 | 28 hb ± 0.00 | 21 je ± 0.05 | 26 ec ± 0.00 | 13 hf ± 0.00 | 26 hc ± 0.05 | 34 ba ± 0.00 |
| B7/Neo a | 36 aa ± 0.05 | 34 ab ± 0.00 | 36 aa ± 0.00 | 33 ac ± 0.00 | 23 gd ± 0.05 | 20 be ± 0.05 | 34 ab ± 0.00 | 36 aa ± 0.00 |
| B8/Tetra d | 25 id ± 0.00 | 29 ec ± 0.00 | 33 da ± 0.05 | 20 kf ± 0.00 | 24 fe ± 0.00 | 15 fg ± 0.00 | 24 je ± 0.00 | 31 cb ± 0.00 |
| B9/Rif bc | 25 if ± 0.00 | 31 db ± 0.05 | 26 je ± 0.00 | 29 cc ± 0.05 | 32 aa ± 0.00 | 13 hh ± 0.05 | 24 jg ± 0.00 | 28 dd ± 0.05 |
| B10/Rif b | 29 ec ± 0.00 | 34 aa ± 0.05 | 27 id ± 0.05 | 24 hg ± 0.05 | 31 bb ± 0.00 | 14 gh ± 0.00 | 25 if ± 0.00 | 26 ee ± 0.05 |
| B11/Poly a | 34 bb ± 0.00 | 33 bc ± 0.00 | 35 ba ± 0.00 | 32 bd ± 0.00 | 32 ad ± 0.05 | 22 ae ± 0.00 | 32 bd ± 0.05 | 34 bb ± 0.00 |
| B12/Poly cd | 33 ca ± 0.05 | 23 hf ± 0.00 | 32 eb ± 0.05 | 19 kg ± 0.00 | 26 ed ± 0.00 | 17 dh ± 0.05 | 29 ec ± 0.10 | 25 fe ± 0.00 |
| B13/Amo cd | 27 gc ± 0.05 | 21 jg ± 0.00 | 35 ba ± 0.00 | 25 ge ± 0.00 | 26 ed ± 0.02 | 16 eh ± 0.00 | 30 db ± 0.00 | 23 gf ± 0.05 |
| B14/Stre bcd | 24 jf ± 0.00 | 25 fe ± 0.05 | 35 ba ± 0.00 | 27 ed ± 0.05 | 23 gg ± 0.00 | 15 fh ± 0.00 | 31 cb ± 0.00 | 28 dc ± 0.00 |
Disclaimer/Publisher’s Note: The statements, opinions and data contained in all publications are solely those of the individual author(s) and contributor(s) and not of MDPI and/or the editor(s). MDPI and/or the editor(s) disclaim responsibility for any injury to people or property resulting from any ideas, methods, instructions or products referred to in the content. |
© 2023 by the authors. Licensee MDPI, Basel, Switzerland. This article is an open access article distributed under the terms and conditions of the Creative Commons Attribution (CC BY) license (https://creativecommons.org/licenses/by/4.0/).
Share and Cite
Kortam, Y.G.; Abd El-Rahim, W.M.; Khattab, A.E.-N.A.; Rebouh, N.Y.; Gurina, R.R.; Barakat, O.S.; Zakaria, M.; Moawad, H. Enhancing the Antibiotic Production by Thermophilic Bacteria Isolated from Hot Spring Waters via Ethyl Methanesulfonate Mutagenesis. Antibiotics 2023, 12, 1095. https://doi.org/10.3390/antibiotics12071095
Kortam YG, Abd El-Rahim WM, Khattab AE-NA, Rebouh NY, Gurina RR, Barakat OS, Zakaria M, Moawad H. Enhancing the Antibiotic Production by Thermophilic Bacteria Isolated from Hot Spring Waters via Ethyl Methanesulfonate Mutagenesis. Antibiotics. 2023; 12(7):1095. https://doi.org/10.3390/antibiotics12071095
Chicago/Turabian StyleKortam, Yasmin G., Wafaa M. Abd El-Rahim, Abd El-Nassar A. Khattab, Nazih Y. Rebouh, Regina R. Gurina, Olfat S. Barakat, Mohamed Zakaria, and Hassan Moawad. 2023. "Enhancing the Antibiotic Production by Thermophilic Bacteria Isolated from Hot Spring Waters via Ethyl Methanesulfonate Mutagenesis" Antibiotics 12, no. 7: 1095. https://doi.org/10.3390/antibiotics12071095
APA StyleKortam, Y. G., Abd El-Rahim, W. M., Khattab, A. E.-N. A., Rebouh, N. Y., Gurina, R. R., Barakat, O. S., Zakaria, M., & Moawad, H. (2023). Enhancing the Antibiotic Production by Thermophilic Bacteria Isolated from Hot Spring Waters via Ethyl Methanesulfonate Mutagenesis. Antibiotics, 12(7), 1095. https://doi.org/10.3390/antibiotics12071095

